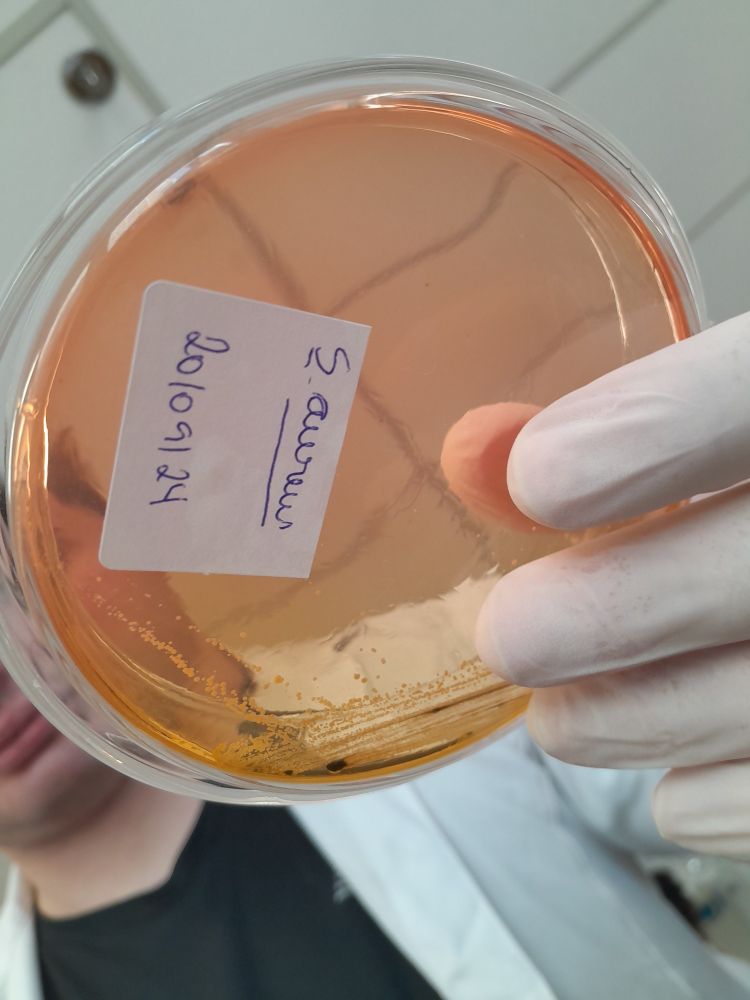
Post image

💀
25.09.2024 14:20 — 👍 0 🔁 0 💬 0 📌 0Biano
@bianoogiovanna.bsky.social
@bianoogiovanna.bsky.social
💀
25.09.2024 14:20 — 👍 0 🔁 0 💬 0 📌 0

Últimos registros da aula de bacteriologia (24/09/2024)
25.09.2024 14:19 — 👍 0 🔁 0 💬 0 📌 0Quase queimei as luvas nessa aula prática (mas amei ver sobre como funciona o método de gram na prática) 🤡🥰
25.09.2024 14:13 — 👍 0 🔁 0 💬 0 📌 0Eu simplesmente havia esquecido de estudar a parte de anatomia, bacteriologia e imunologia estavam tão boas... que meu cérebro deletou o fato de eu precisar estudar sobre ele também! 😰
25.09.2024 14:09 — 👍 0 🔁 0 💬 0 📌 0
Amo essas 🧟♂️🧛♂️
22.09.2024 03:39 — 👍 0 🔁 0 💬 0 📌 0Antigamente eu conseguia admnistrar 6 trabalhos da escola e um dia, agora na faculdade to dando conta nem de 1 durante a semana (professores já passaram uns 4
16.09.2024 15:35 — 👍 0 🔁 0 💬 0 📌 0

+1 prática
16.09.2024 15:32 — 👍 0 🔁 0 💬 0 📌 0Todo dia é um gif novo, antes era do "ja morreu", depois o da cachoeira e agora a terra pegando fogo
16.09.2024 15:31 — 👍 0 🔁 0 💬 0 📌 0
Tome mais práticas 🔬💪🏻
10.09.2024 22:21 — 👍 0 🔁 0 💬 0 📌 0 10.09.2024 01:33 — 👍 0 🔁 0 💬 0 📌 0
10.09.2024 01:33 — 👍 0 🔁 0 💬 0 📌 0
Queria ter a rotina de uma blogueirinha milionária, só ia ter de me preocupar com os stories, posts e se o filtro tava pegando 🫠
10.09.2024 01:31 — 👍 0 🔁 0 💬 0 📌 0
Queria poder postar os vídeos, o tanto de velha que tava gritando e se jogando pro ATOR do Elvis kkkkkkkkk
09.09.2024 00:09 — 👍 0 🔁 0 💬 0 📌 0Meu pai me chamou para ir ao show cover do Elvis hoje, eu jurava que conhecia apenas 3 musicas dele... e agora ouvindo a playlist, posso afirmar que conheço até pelo menos 3 albuns 🎸🕺
08.09.2024 13:07 — 👍 0 🔁 0 💬 0 📌 0


Primeiro dia de aula prática que delícia 😎
06.09.2024 19:35 — 👍 0 🔁 0 💬 0 📌 0Quando será que liberam os vídeos aqui? To querendo postar um bucado 🫠
05.09.2024 19:43 — 👍 0 🔁 0 💬 0 📌 0